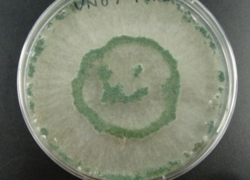

第8回(令和3年度)日本菌学会関東支部勝本賞募集要項
勝本賞は、菌学の推進を奨励するために菌類の研究、教育、普及に貢献している関東支部会員、または支部に関連する研究会や同好会等の団体に授けられる賞であり、その年度ごとに受賞候補対象の分野・基準を決め、募集を行い選考します。ここに、第8回勝本賞受賞候補者を下記の通り募集いたします。ふるってご応募下さい。
記
1. 第8回(令和3年度)勝本賞の受賞候補対象の分野および基準:
- 優れた菌類の写真を撮影した関東支部会員に授与する(勝本賞、優秀賞、佳作各1名)。
- *応募された写真作品から支部会員の投票によって優れた3作品を候補作品とし、その後に選考委員会において各賞を決定します。
2. 応募方法:
- 応募する写真は一人1作品、未発表・未公表のものに限ります。写真作品にはタイトル並びに短いコメントを付け、稲葉宛(下記送付先)にメール添付(ファイルサイズは9MB以下)で送付して下さい。なお、受賞した写真作品は、関東支部のホームページ等に掲載される可能性があることをご了承下さい。
- 写真作品送付先:
- 日本菌学会関東支部 稲葉 重樹 宛
- E-mail: inaba-shigeki@nite.go.jp(@を半角に直してください)
- *作品受領の返信メールが届かなかった場合は、以下のメールアドレスにもお問い合わせ下さい。
- E-mail: viva_oomycetes@jcom.home.ne.jp (@を半角に直してください)
3. 応募締切:令和4年1月31日(月)
4. 授与式:令和4年度年次大会において
勝本賞選考細則(こちらもご覧下さい)
以上
応募例
タイトル:トリコデルマもにっこりTrichodermaコメント:平板培地に生育した菌糸体上の分生子が偶然にヒトの顔のようになりました。 |
タイトル:苔の野原に咲くヒナノヒガサ |
タイトル:キクラゲをおいしく頂きました by ブドウフウセンホコリブドウフウセンホコリ(別名:キノコナカセホコリ)コメント:変形体がしばしば担子菌類の子実体を分解して成長することから。 |